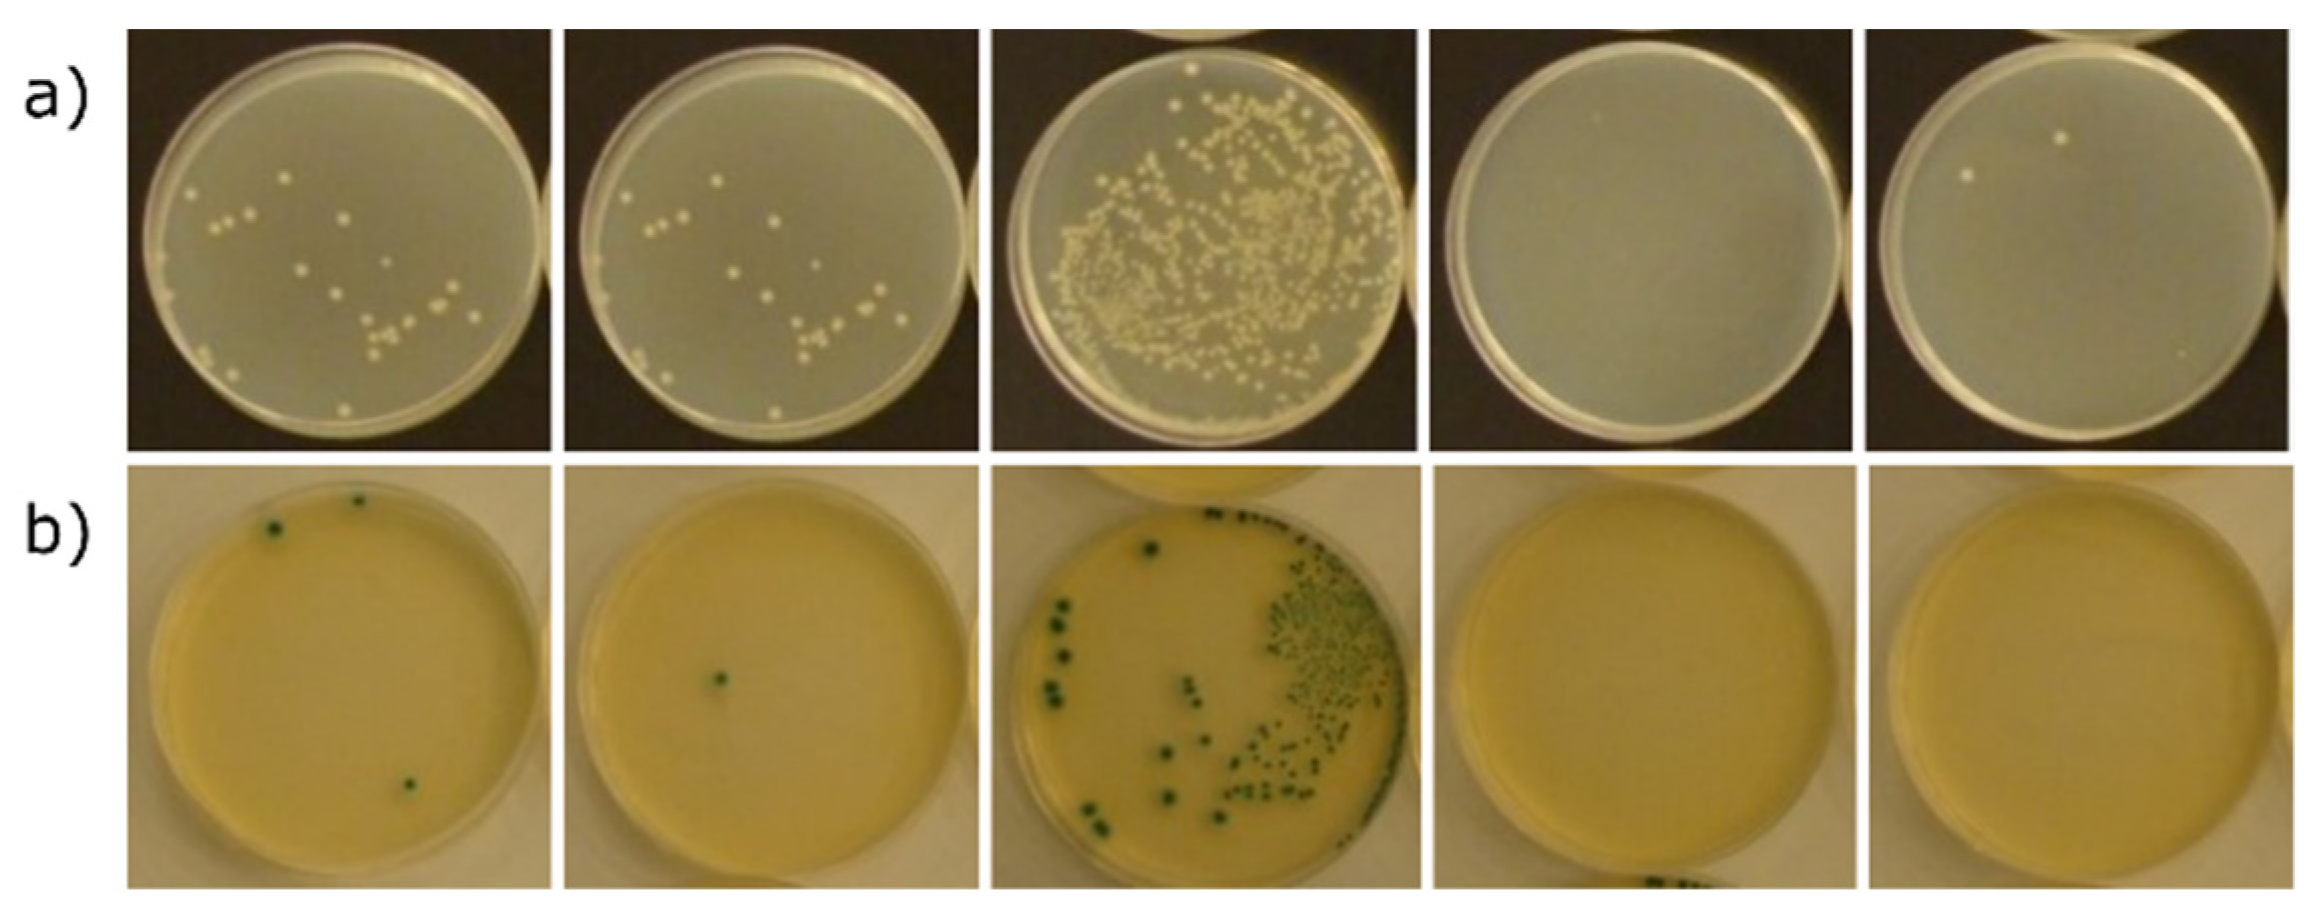
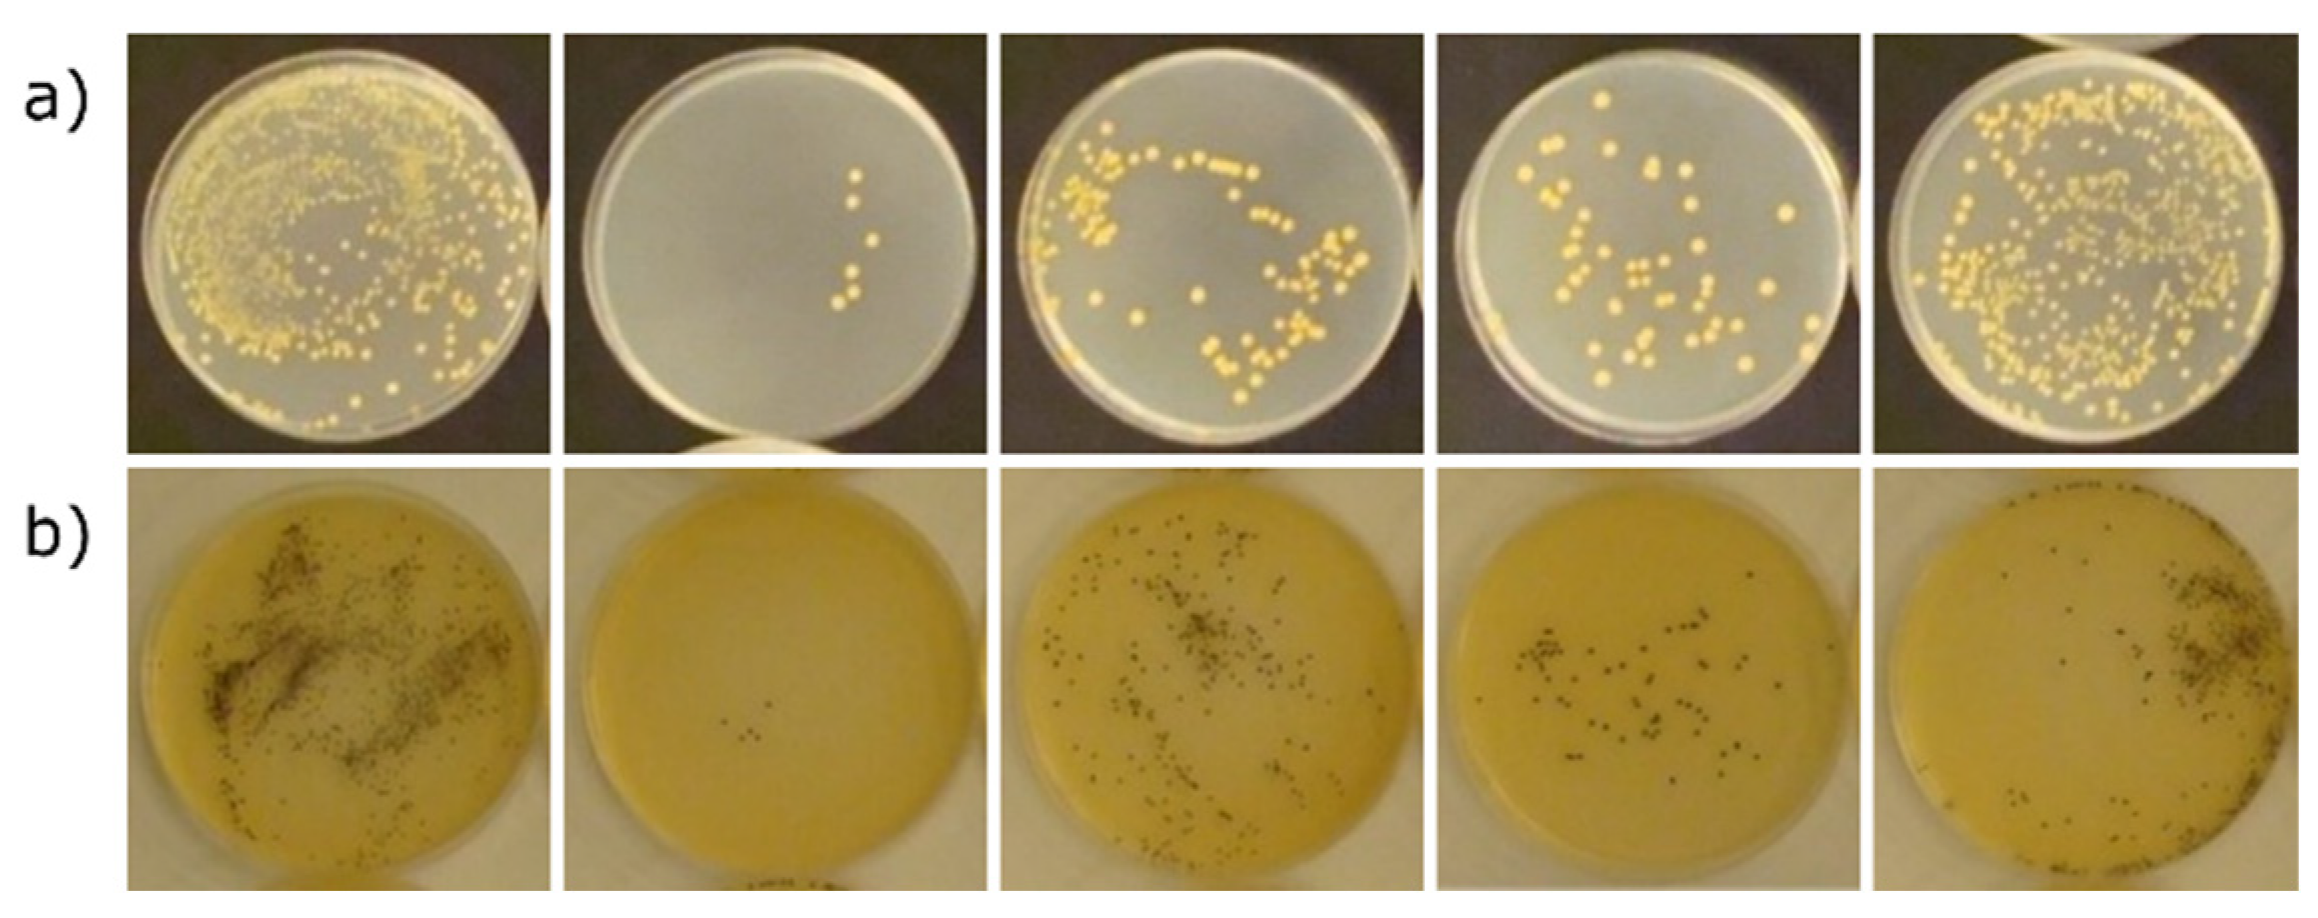

Zeolite-Supported Aggregate as Potential Antimicrobial Agents in Gypsum Composites
Abstract
:1. Introduction
2. Materials and Methods
2.1. Preparation of Aggregate
2.2. Preparation of Gypsum Composites
- 25 × 25 × 100 mm bars for strength tests according to EN 13279-2:2014 standard;
- A 75 × 75 × 15 mm plate for testing the thermal conductivity according to the EN 12667 standard;
- 10 × 40 × 40 mm samples for antibacterial tests according to the ISO 22196:2011 standard.
2.3. Instrumentation
3. Results and Discussion
3.1. Physicochemical Properties of Zeolite Aggregate
3.2. Physical and Mechanical Properties of Gypsum Composites
3.3. Antimicrobial Properties of Gypsum Composites
4. Conclusions
- The color of the aggregate is lighter than that of the typical gypsum binder; use may be limited by the color variants of the aggregate.
- The aggregates assessed showed good embedding of the grains in the gypsum binder matrix.
- Based on the method of breaking, the zeolite aggregate showed a lower strength than that of the gypsum binder. The effect of introducing active ions into the zeolite structure is negligible.
- Gypsum composites based on the zeolite aggregate are characterized by an appropriate strength, reduced density, and a thermal conductivity that is appropriate for gypsum plasters. Its properties resemble those of perlite. The proposed aggregate was evaluated as being useful in building materials technologies, both for small-size cast elements and for plaster.
- The antibacterial activity tests conducted against two reference strains of Staphylococcus aureus and Escherichia coli bacteria did not fully confirm the antibacterial effectiveness of the tested formulations after their incorporation into the plaster layer. On the other hand, a noticeable bacteriostatic effect was found for the formulations with copper and zinc against Escherichia coli and with copper against Staphylococcus aureus.
- The research carried out also revealed a certain gap in the methodology of antibacterial determinations related to the analyses carried out on porous materials.
Author Contributions
Funding
Institutional Review Board Statement
Informed Consent Statement
Data Availability Statement
Conflicts of Interest
Sample Availability
References
- Wang, W.; Schnoor, J.L.; Doi, J. Volatile Organic Compounds in the Environment; ASTM International: West Conshohocken, PA, USA, 1996; Volume 1261, pp. 7–32. [Google Scholar]
- Dutta, P.; Wang, B. Zeolite-supported silver as antimicrobial agents. Coord. Chem. Rev. 2019, 383, 1–29. [Google Scholar] [CrossRef]
- Zhou, Y.; Deng, Y.; He, P.; Dong, F.; Xia, Y.; He, Y. Antibacterial zeolite with a high silver-loading content and excellent antibacterial performance. RSC Adv. 2014, 4, 5283–5288. [Google Scholar] [CrossRef]
- Sezemans, G.; Sinica, M.; Zacharčenko, P.; Pivenj, N.; Mikulskis, D.; Kligys, M. Influence of zeolite additive on the properties of plaster used for external walls from autoclaved aerated concrete. Mater. Sci. 2013, 19, 222–229. [Google Scholar] [CrossRef] [Green Version]
- Demirci, S.; Ustaoğlu, Z.; Yılmazer, G.A.; Sahin, F.; Baç, N. Antimicrobial properties of zeolite-X and zeolite-A ion-exchanged with silver, copper, and zinc against a broad range of microorganisms. Appl. Biochem. Biotechnol. 2014, 172, 1652–1662. [Google Scholar] [CrossRef]
- Zhang, Y.; Zhong, S.; Zhang, M.; Lin, Y. Antibacterial activity of silver-loaded zeolite A prepared by a fast microwave-loading method. J. Mater. Sci. 2009, 44, 457–462. [Google Scholar] [CrossRef]
- Kwakye-Awuah, B.; Williams, C.; Kenward, M.; Radecka, I. Antimicrobial action and efficiency of silver-loaded zeolite X. J. Appl. Microbiol. 2008, 104, 1516–1524. [Google Scholar] [CrossRef]
- Malachová, K.; Praus, P.; Rybková, Z.; Kozák, O. Antibacterial and antifungal activities of silver, copper and zinc montmorillonites. Appl. Clay Sci. 2011, 53, 642–645. [Google Scholar] [CrossRef]
- Hrenovic, J.; Milenkovic, J.; Ivankovic, T.; Rajic, N. Antibacterial activity of heavy metal-loaded natural zeolite. J. Hazard. Mater. 2012, 201, 260–264. [Google Scholar] [CrossRef]
- Top, A.; Ülkü, S. Silver, zinc, and copper exchange in a Na-clinoptilolite and resulting effect on antibacterial activity. Appl. Clay Sci. 2004, 27, 13–19. [Google Scholar] [CrossRef] [Green Version]
- Iyigundogdu, Z.; Demirci, S.; Baç, N.; Sahin, F. Development of durable antimicrobial surfaces containing silver- and zinc-ion-exchanged zeolites. Turk. J. Biol. 2014, 38, 420–427. [Google Scholar] [CrossRef]
- Sophia, M.; Sakthieswaran, N. Synergistic effect of mineral admixture and bio-carbonate fillers on the physico-mechanical properties of gypsum plaster. Constr. Build. Mater. 2019, 204, 419–439. [Google Scholar] [CrossRef]
- Egorova, A.D.; Filippova, K.E. Ultra-disperse modifying zeolite-based additive for gypsum concrete, International Conference on Construction, Architecture and Technosphere Safety. Mater. Sci. Eng. 2019, 687, 022030. [Google Scholar]
- Khan, M.I. Factors affecting the thermal properties of concrete and applicability of its prediction models. Build. Environ. 2002, 37, 607–614. [Google Scholar] [CrossRef]
- Park, S.K.; Kim, J.H.J.; Namb, J.W.; Phan, H.D.; Kim, J.K. Development of anti-fungal mortar and concrete using zeolite and zeocarbon microcapsules. Cem. Concr. Compos. 2009, 31, 447–453. [Google Scholar] [CrossRef]
- Król, M.; Mikuła, A. Synthesis of the zeolite granulate for potential sorption application. Microporous Mesoporous Mater. 2017, 243, 201–205. [Google Scholar] [CrossRef]
- Król, M. Hydrothermal synthesis of zeolite aggregate with potential use as a sorbent of heavy metal cations. J. Mol. Struct. 2019, 1183, 353–359. [Google Scholar] [CrossRef]
- Mozgawa, W.; Bajda, T. Spectroscopic study of heavy metals sorption on clinoptilolite. Phys. Chem. Miner. 2005, 31, 706–713. [Google Scholar] [CrossRef]
- Moreno, N.; Querol, X.; Plana, F.; Andres, J.M.; Janssen, M.; Nugteren, H. Pure zeolite synthesis from silica extracted from coal fly ashes. J. Chem. Technol. Biotechnol. 2002, 77, 274. [Google Scholar] [CrossRef]
- Cardoso, A.M.; Paprocki, A.; Ferret, L.S.; Azevedo, C.M.N.; Pires, M. Synthesis of zeolite Na-P1 under mild conditions using Brazilian coal fly ash and its application in wastewater treatment. Fuel 2015, 139, 59–67. [Google Scholar] [CrossRef]
- Mertens, G.; Snellings, R.; Van Balen, K.; Bicer-Simsir, B.; Verlooy, P.; Elsen, J. Pozzolanic reactions of common natural zeolites with lime and parameters affecting their reactivity. Cem. Concr. Res. 2009, 39, 233–240. [Google Scholar] [CrossRef]
- Pavlík, V.; Užáková, M. Use of zeolite dust in lime mortars. Inzynieria Miner. 2013, 2, 31–36. [Google Scholar]
- Król, M. A novel lightweight aggregate containing zeolite with potential use in gypsum composites. Mater Struct. 2022, 55, 89. [Google Scholar] [CrossRef]
- Doleželová, M.; Krejsová, J.; Vimmrova, A. Lightweight gypsum based materials: Methods of preparation and utilization. Int. J. Sus. Dev. Plann. 2017, 12, 326–335. [Google Scholar] [CrossRef] [Green Version]
- Colak, A. Density and strength characteristics of foamed gypsum. Cem. Concr. Compos. 2000, 22, 193–200. [Google Scholar] [CrossRef]
- Baspınar, M.S.; Kahraman, E. Modifications in the properties of gypsum construction element via addition of expanded macroporous silica granules. Constr. Build. Mater. 2011, 25, 3327–3333. [Google Scholar] [CrossRef]
- Raggiottia, B.B.; Positieria, M.S.; Oshiro, Á. Natural zeolite, a pozzolan for structural concrete. Procedia Struct. Integr. 2018, 11, 36–43. [Google Scholar] [CrossRef]
- Ramezanianpour, A.A.; Amirani, M.M.Z.; Mirvalad, S. Zeolite containing mortars reinforced with graphene oxide synthesized by hydrolysis of tetraethyl orthosilicate. J. Mater. Civil Eng. 2022, 34, 04022078. [Google Scholar] [CrossRef]
- Lourenço, P.B.; Hees, R.; Fernandes, F.; Lubelli, B. Characterization and damage of brick masonry. In Structural Rehabilitation of Old Buildings. Building Pathology and Rehabilitation; Costa, A., Guedes, J.M., Varum, H., Eds.; Springer: Berlin/Heidelberg, Germany, 2014; pp. 109–130. [Google Scholar]
- Buratti, C.; Moretti, E.; Belloni, E.; Agosti, F. Development of Innovative aerogel based plasters: Preliminary thermal and acoustic performance evaluation. Sustainability 2014, 6, 5839–5852. [Google Scholar] [CrossRef] [Green Version]
- Yao, G.; Lei, J.; Zhang, W.; Yu, C.; Sun, Z.; Zheng, S.; Komarneni, S. Antimicrobial activity of X zeolite exchanged with Cu2+ and Zn2+ on Escherichia coli and Staphylococcus aureus. Environ. Sci. Pollut. Res. 2019, 26, 2782–2793. [Google Scholar] [CrossRef]
- Cui, J.; Yeasmin, R.; Shao, Y.; Zhang, H.; Zhang, H.; Zhu, J. Fabrication of Ag+, Cu2+, and Zn2+ ternary ion-exchanged zeolite as an antimicrobial agent in powder coating. Ind. Eng. Chem. Res. 2020, 59, 751–762. [Google Scholar] [CrossRef]
- Peixoto, P.; Guedes, J.F.; Rombi, E.; Fonseca, A.M.; Aguiar, C.A.; Neves, I.C. Metal ion-zeolite materials against resistant bacteria, MRSA. Ind. Eng. Chem. Res. 2021, 60, 12883–12892. [Google Scholar] [CrossRef]
- Cerri, G.; Farina, M.; Brundu, A.; Gavini, E.; Salis, A.; Dathe, W. Antibacterial activity of Zn-loaded Cuban zeolite against Helicobacter pylori in comparison to its Na-loaded and unmodified counterparts. Environ. Geochem. Health 2021, 43, 2037–2048. [Google Scholar] [CrossRef] [PubMed]
- Reyes-Jara, A.; Cordero, N.; Aguirre, J.; Troncoso, M.; Figueroa, G. Antibacterial effect of copper on microorganisms isolated from bovine mastitis. Front. Microbiol. 2016, 7, 626. [Google Scholar] [CrossRef] [PubMed] [Green Version]
- Dolic, M.B.; Rajakovic-Ognjanovic, V.N.; Strbac, S.B.; Dimitrijevic, S.I.; Mitric, M.N.; Onjia, A.E.; Rajakovic, L.V. Natural sorbents modified by divalent Cu2+- and Zn2+-ions and their corresponding antimicrobial activity. New Biotechnol. 2017, 39, 150–159. [Google Scholar] [CrossRef] [Green Version]
- Maleki-Ghaleh, H.; Siadati, M.H.; Fallah, A.; Koc, B.; Kavanlouei, M.; Khademi-Azandehi, P.; Moradpur-Tari, E.; Omidi, Y.; Barar, J.; Beygi-Khosrowshahi, Y.; et al. Antibacterial and cellular behaviors of novel zinc-doped hydroxyapatite/graphene Nanocomposite for bone tissue engineering. Int. J. Mol. Sci. 2021, 22, 9564. [Google Scholar] [CrossRef]

| Sample | SiO2 | TiO2 | Al2O3 | Fe2O3 | MgO | CaO | Na2O | K2O | NiO | CuO | ZnO | Res. |
|---|---|---|---|---|---|---|---|---|---|---|---|---|
| Na-Z | 47.80 | 0.32 | 12.59 | 1.56 | 2.90 | 25.51 | 7.88 | 0.13 | 0.07 | 0.06 | 0.16 | 1.02 |
| Ni-Z | 45.35 | 0.24 | 10.10 | 1.28 | 3.12 | 21.16 | 3.19 | 0.15 | 14.22 | 0.06 | 0.15 | 0.98 |
| Cu-Z | 41.92 | 0.24 | 9.31 | 1.33 | 3.04 | 21.04 | 2.13 | 0.13 | 0.00 | 19.15 | 0.12 | 1.59 |
| Zn-Z | 45.18 | 0.28 | 9.63 | 1.26 | 3.18 | 20.91 | 3.99 | 0.15 | 0.30 | 0.30 | 14.25 | 0.57 |
| Sample | Bulk Density, (g/cm3) | Flexural Strength, (MPa) | Compressive Strength, (MPa) | Hardness, (MPa) | Water Absorption, (%) | Softening Factor | Thermal Conductivity, (W/(m·K)) |
|---|---|---|---|---|---|---|---|
| Na-Z | 1.05 ± 0.01 | 1.07 ± 0.06 | 4.04 ± 0.72 | 8.1 ± 1.0 | 27.32 | 0.48 ± 0.02 | 0.313 |
| Ni-Z | 1.05 ± 0.01 | 1.24 ± 0.06 | 4.83 ± 0.26 | 7.0 ± 0.9 | 27.20 | 0.49 ± 0.02 | 0.293 |
| Cu-Z | 1.10 ± 0.02 | 1.86 ± 0.09 | 5.54 ± 0.41 | 8.3 ± 0.7 | 25.97 | 0.44 ± 0.02 | 0.299 |
| Zn-Z | 1.06 ± 0.01 | 0.98 ± 0.05 | 4.65 ± 0.80 | 8.6 ± 0.6 | 27.15 | 0.50 ± 0.02 | 0.305 |
| perlite | 0.91 ± 0.01 | 1.08 ± 0.06 | 2.93 ± 0.18 | 6.8 ± 1.2 | 31.38 | 0.46 ± 0.02 | 0.236 |
| Sample | Escherichia coli | Staphylococcus aureus |
|---|---|---|
| Na-Z | 0.22 | 1.98 |
| Ni-Z | 0.42 | 0.98 |
| Cu-Z | 1.68 | 1.42 |
| Zn-Z | 1.23 | 0.72 |
Publisher’s Note: MDPI stays neutral with regard to jurisdictional claims in published maps and institutional affiliations. |
© 2022 by the authors. Licensee MDPI, Basel, Switzerland. This article is an open access article distributed under the terms and conditions of the Creative Commons Attribution (CC BY) license (https://creativecommons.org/licenses/by/4.0/).
Share and Cite
Król, M.; Syguła-Cholewińska, J.; Sawoszczuk, T. Zeolite-Supported Aggregate as Potential Antimicrobial Agents in Gypsum Composites. Materials 2022, 15, 3305. https://doi.org/10.3390/ma15093305
Król M, Syguła-Cholewińska J, Sawoszczuk T. Zeolite-Supported Aggregate as Potential Antimicrobial Agents in Gypsum Composites. Materials. 2022; 15(9):3305. https://doi.org/10.3390/ma15093305
Chicago/Turabian StyleKról, Magdalena, Justyna Syguła-Cholewińska, and Tomasz Sawoszczuk. 2022. "Zeolite-Supported Aggregate as Potential Antimicrobial Agents in Gypsum Composites" Materials 15, no. 9: 3305. https://doi.org/10.3390/ma15093305
APA StyleKról, M., Syguła-Cholewińska, J., & Sawoszczuk, T. (2022). Zeolite-Supported Aggregate as Potential Antimicrobial Agents in Gypsum Composites. Materials, 15(9), 3305. https://doi.org/10.3390/ma15093305

